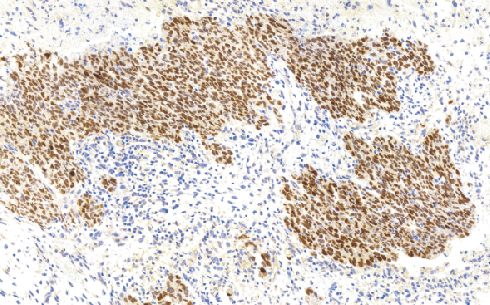
产品细节图片1

万千商家帮你免费找货
0 人在求购买到急需产品
- 详细信息
- 文献和实验
- 技术资料
- 形态:
Liquit
- 保存条件:
-20℃
- 克隆性:
单克隆
- 适应物种:
Human,(predicted:Mouse,Rat,)
- 保质期:
1年
- 抗原来源:
peptiede
- 目录编号:
TDCMM-0121
- 级别:
科研级
- 库存:
88
- 供应商:
武汉天德
- 宿主:
鼠
- 应用范围:
WB=1:500-1000
- 浓度:
1mg/ml
- 抗体英文名:
MDM2 Protein
- 抗体名:
MDM2 Protein
- 规格:
1ml工作液
MDM2 Protein鼠抗人MDM2蛋白单克隆抗体
MDM2是一种泛素连接酶,位于12号染色体长臂。免疫组化检测MDM2高表达,对诊断高分化脂肪瘤和去分化脂肪肉瘤具有一定的价值。但是,在部分梭形细胞肉瘤或者多形性肉瘤中,该抗体也可以表达阳性,如恶性外周神经鞘膜瘤、粘液纤维肉瘤和横纹肌肉瘤。因此,MDM2和CDK4可联合检测,共同鉴定高分化的脂肪肉瘤和去分化的脂肪肉瘤。
- 货号:TDCMM-0121
- 克隆号:BSB-64
- 阳性部位:胞核
- 适用组织:石蜡切片 /冰冻切片
- 预处理:热修复
风险提示:丁香通仅作为第三方平台,为商家信息发布提供平台空间。用户咨询产品时请注意保护个人信息及财产安全,合理判断,谨慎选购商品,商家和用户对交易行为负责。对于医疗器械类产品,请先查证核实企业经营资质和医疗器械产品注册证情况。
文献和实验抗体使用小技巧_技术资料_丁香通 (biomart.cn)
是一种抑癌蛋白,而mdm2 是一种癌蛋白,mdm2 能抑制P53转录并促进其水解,而P53能加强mdm2的转录水平和蛋白水平,这样形成一个负馈环路,所以P53在生物体内含量很低的。反建议百度 P53-MDM2,最好看那些文献综述,里面讲的比较详细 小小小白兔 非常感谢你,谢谢你。你肯定对他两的关系了解的很深,可否发给我一些实用性强的文献,想在背景知识了讲一些基础的知识,谢谢。联系:913777171@qq.com 小红赛
【求助】P53的翻译后修饰都有哪些? 怎样验证其修饰后与靶标启动子的结合活性的变化?
质功能的一个主要机制,p53在多个位点上可被磷酸化、顺-反异构化、乙酰化、泛素化、甲基化、糖基化等修饰,从而显示其生物学重要性。这种显示细胞或组织特异性并依赖细胞周期位置的多重修饰,是一种复杂的调节方式,随着细胞对DNA损伤、增殖、老化等产生的细胞信号的反应而发生波动。 磷酸化修饰 P53的磷酸化在多数情况下与蛋白质的稳定性有关。p53 N-末端的三个位点Ser15、Thr18、Ser20磷酸化后,使p53和其主要的负性调节因子MDM2之间的相互作用消失,而和乙
三句话读懂一篇 CNS:「神药」二甲双胍又出抗癌奇招;抑郁症
through reducing the RPL11-MDM2-p53 signaling。该研究揭示了一个新的肝癌癌基因——核糖体生物合成调节因子 RRS1(Ribosome biogenesis regulator 1 homolog),发生于拷贝数扩增的染色体 8q 区域,证明该基因通过抑制 RPL11-MDM2-p53 信号转导通路促进肝癌发展!愿肝癌早日被攻克,还人类以健康!图 1:来源 Science Advances2. Nature Communications:发现一种新的促长寿超长链饱和脂肪酸脂代谢和生物
技术资料暂无技术资料 索取技术资料









